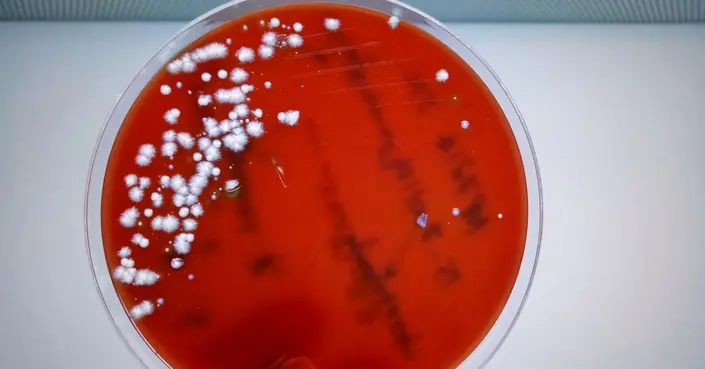

يُعتقد غالبًا أن داء المبيضات، المعروف أيضًا بعدوى الخميرة أو القلاع، هو مشكلة صحية تؤثر على النساء فقط. ومع ذلك، يمكن للرجال أيضًا الإصابة بهذه العدوى الفطرية المزعجة، والتي قد تتسبب في إحراج وعدم راحة إذا لم تُعالج بشكل صحيح.
في هذا الدليل الشامل، سنستعرض كل ما يهمك معرفته حول داء المبيضات عند الرجال، بدءًا من أسبابه وعوامل الخطر التي تزيد من فرص الإصابة به، وصولًا إلى الأعراض التي يجب الانتباه إليها وطرق العلاج الفعالة، بالإضافة إلى نصائح عملية للوقاية منه.
جدول المحتويات
- ما هو داء المبيضات عند الرجال؟
- أسباب داء المبيضات عند الرجال
- عوامل الخطر لداء المبيضات الذكوري
- أعراض داء المبيضات عند الرجال
- خيارات علاج داء المبيضات عند الرجال
- متى يصبح داء المبيضات خطيراً؟
- نصائح للوقاية من داء المبيضات عند الرجال
ما هو داء المبيضات عند الرجال؟
داء المبيضات هو عدوى فطرية يسببها نوع من الخميرة يُعرف باسم المبيضات البيضاء (Candida albicans). هذه الفطريات تتواجد بشكل طبيعي على الجلد وفي الفم والجهاز الهضمي بكميات صغيرة.
عند الرجال، يمكن أن تؤثر العدوى بشكل خاص على رأس القضيب (الحشفة) والقلفة، وقد تؤدي إلى حالة تُعرف بالتهاب الحشفة. من المهم معرفة أن هذه العدوى لا تقتصر على النساء وقد تصيب الرجال من جميع الأعمار.
أسباب داء المبيضات عند الرجال
تحدث معظم حالات داء المبيضات عندما ينمو فطر المبيضات البيضاء بشكل مفرط. على الرغم من أن هذا الفطر جزء طبيعي من الجسم، إلا أن ظروفًا معينة يمكن أن تحفز تكاثره السريع، مما يؤدي إلى العدوى.
فطر المبيضات البيضاء
عادة ما تبقى أعداد فطر المبيضات تحت السيطرة بفضل جهاز المناعة والبكتيريا المفيدة الأخرى في الجسم. ومع ذلك، عندما تصبح البيئة دافئة ورطبة بشكل مفرط، أو عندما يضعف الجهاز المناعي، يمكن أن ينمو هذا الفطر بسرعة أكبر مما يستطيع الجسم مقاومته.
أماكن شيوع العدوى بالفطريات
تتركز عدوى المبيضات غالبًا في المناطق الدافئة والرطبة من الجسم. عند الرجال، تشمل هذه المناطق:
- الفم والحلق والمريء: تعرف هذه الحالة بـ “القلاع الفموي”.
- ثنيات الجلد: مثل المنطقة بين الأصابع، أو تحت الإبطين، أو في ثنيات الجلد الناتجة عن السمنة.
- المنطقة التناسلية: خاصة تحت القلفة وعلى رأس القضيب.
عوامل الخطر لداء المبيضات الذكوري
تزيد بعض العوامل من احتمالية إصابة الرجال بداء المبيضات، وتشمل:
- ضعف النظافة الشخصية: يمكن أن يؤدي إهمال النظافة إلى تراكم الرطوبة وتوفير بيئة مثالية لنمو الفطريات.
- السمنة: تتسبب السمنة في وجود ثنيات جلدية إضافية، والتي تصبح مناطق دافئة ورطبة ومناسبة لتكاثر الفطريات.
- مرض السكري: يؤدي ارتفاع مستويات السكر في الدم إلى توفير بيئة غنية بالسكر، مما يعزز نمو المبيضات.
- ضعف الجهاز المناعي: حالات مثل الإصابة بفيروس نقص المناعة البشرية (HIV)، أو تلقي علاجات السرطان (العلاج الكيميائي أو الإشعاعي)، أو تناول أدوية مثبطة للمناعة، تضعف قدرة الجسم على مكافحة العدوى.
- استخدام المضادات الحيوية لفترات طويلة: يمكن للمضادات الحيوية أن تقضي على البكتيريا النافعة التي تساعد في السيطرة على نمو المبيضات، مما يتيح للفطريات التكاثر بحرية.
- ممارسة العلاقة الحميمة مع شريك مصاب: تنتقل العدوى بسهولة بين الشريكين أثناء الجماع إذا كان أحدهما مصابًا.
أعراض داء المبيضات عند الرجال
تختلف أعراض داء المبيضات من شخص لآخر، ولكنها عادة ما تشمل الآتي:
- الحكة والحرقان: شعور مزعج بالحكة والحرقان حول رأس القضيب، يزداد سوءًا غالبًا بعد ممارسة الجماع.
- الاحمرار والتورم: تظهر المنطقة المصابة حمراء ومتورمة بشكل واضح.
- ظهور نتوءات صغيرة: قد تظهر نتوءات صغيرة تشبه الطفح الجلدي وتسمى حطاطات، وقد تحتوي هذه النتوءات أحيانًا على صديد.
- الألم والحرقان أثناء التبول: قد يشعر الرجل بألم أو إحساس بالحرقان عند التبول.
أعراض أكثر حدة لمرضى السكري
الرجال المصابون بمرض السكري قد يعانون من أعراض أكثر شدة، مثل تراكم السوائل، وتقرح القضيب، وحتى تشقق القلفة. يجب على هؤلاء الأفراد توخي حذر خاص والبحث عن العلاج الفوري.
خيارات علاج داء المبيضات عند الرجال
عادة ما يكون علاج داء المبيضات بسيطًا وفعالًا، ويتضمن الخطوات التالية:
- الكريمات المضادة للفطريات: تُستخدم كريمات موضعية تحتوي على مضادات الفطريات للمساعدة في التخلص من العدوى. يستغرق العلاج عادة من 7 إلى 10 أيام.
- مستحضرات تخفيف الحكة: إذا كانت الحكة شديدة، قد يصف الطبيب مستحضرًا لتخفيف هذا الشعور المزعج.
- تجنب الجماع: يُنصح بتجنب ممارسة العلاقة الحميمة حتى التعافي التام من العدوى لمنع انتشارها ولتجنب تهيج المنطقة المصابة.
متى يصبح داء المبيضات خطيراً؟
في معظم الحالات، تكون عدوى المبيضات موضعية وغير خطيرة. ومع ذلك، يمكن أن تصبح مشكلة صحية خطيرة في ظروف معينة، خاصة إذا انتشرت الفطريات إلى مجرى الدم.
المضاعفات المحتملة والمعرضون لها
إذا كان الجهاز المناعي ضعيفًا، هناك خطر من أن تنتشر الفطريات في مجرى الدم، وهي حالة تعرف باسم الفطريات الجهازية. هذه حالة خطيرة تتطلب علاجًا فوريًا. تزداد فرص الإصابة بهذه المضاعفات في الحالات التالية:
- الإصابة بفيروس نقص المناعة البشرية (HIV).
- الإصابة بمرض السكري غير المتحكم فيه.
- تلقي العلاج الكيميائي أو الإشعاعي.
- تناول الأدوية المثبطة للمناعة.
في هذه الحالات، يجب البحث عن الرعاية الطبية الفورية لمنع تفاقم الحالة.
نصائح للوقاية من داء المبيضات عند الرجال
يمكنك تقليل خطر الإصابة بداء المبيضات باتباع بعض النصائح الوقائية البسيطة:
- الحفاظ على النظافة الشخصية: اغسل منطقة الأعضاء التناسلية بانتظام بالماء الدافئ.
- التجفيف الجيد: تأكد من تجفيف القضيب والمنطقة المحيطة به جيدًا بعد الاستحمام أو السباحة، فالرطوبة بيئة مثالية لنمو الفطريات.
- استخدام صابون لطيف: استخدم صابونًا خاليًا من العطور والمواد الكيميائية القاسية لتجنب تهيج الجلد.
- ارتداء ملابس داخلية قطنية: تساعد الملابس الداخلية القطنية على امتصاص الرطوبة وتسمح بتهوية جيدة للمنطقة.
- إدارة الأمراض المزمنة: إذا كنت مصابًا بمرض السكري، حافظ على مستويات السكر في الدم ضمن المعدل الطبيعي.
- تجنب مشاركة الأدوات الشخصية: لا تشارك المناشف أو أدوات النظافة الشخصية مع الآخرين.
- الوعي بالجماع الآمن: استخدم الواقي الذكري إذا كان هناك شك في إصابة الشريك، وتجنب الجماع إذا كنت أنت أو شريكك تعانيان من العدوى.
باتباع هذه الإرشادات، يمكنك تقليل فرص الإصابة بداء المبيضات والحفاظ على صحتك.
في الختام، داء المبيضات عند الرجال هو حالة قابلة للعلاج والوقاية منها. من خلال فهم الأسباب، والتعرف على الأعراض، واتباع أساليب الوقاية الصحيحة، يمكنك الحفاظ على صحتك وراحتك. لا تتردد في استشارة أخصائي الرعاية الصحية إذا كنت تشك في إصابتك بالعدوى أو إذا كانت الأعراض تستمر أو تسوء.